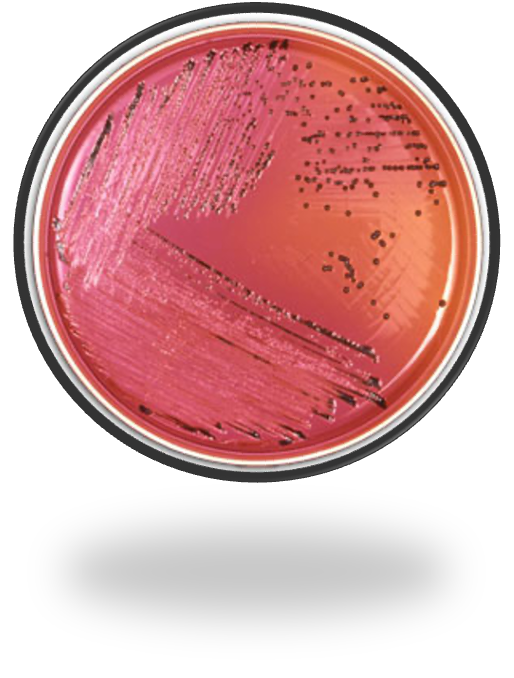

1
Q
A
Agar XLD (xilosa, lisina, desoxicolato)
Shigella y salmonella
2
Q
Especies de salmonella
A

3
Q
Enfermedad severa
A
10-15%
4
Q
FR
A

5
Q
Fisiopatología
A

6
Q
Cuadro clínico
A

7
Q
Presentación clínica fiebre entérica
A

8
Q
Maniofestaciones EI
A

9
Q
Diagnostico
A

10
Q
Indicaciones de Tratamiento salmonella
A

11
Q
Tx
A
Primera opción
Ceftriaxona 2 gr/día
Ciprofloxacino 20mg/Kg/día
12
Q
Portadores crónicos
A



